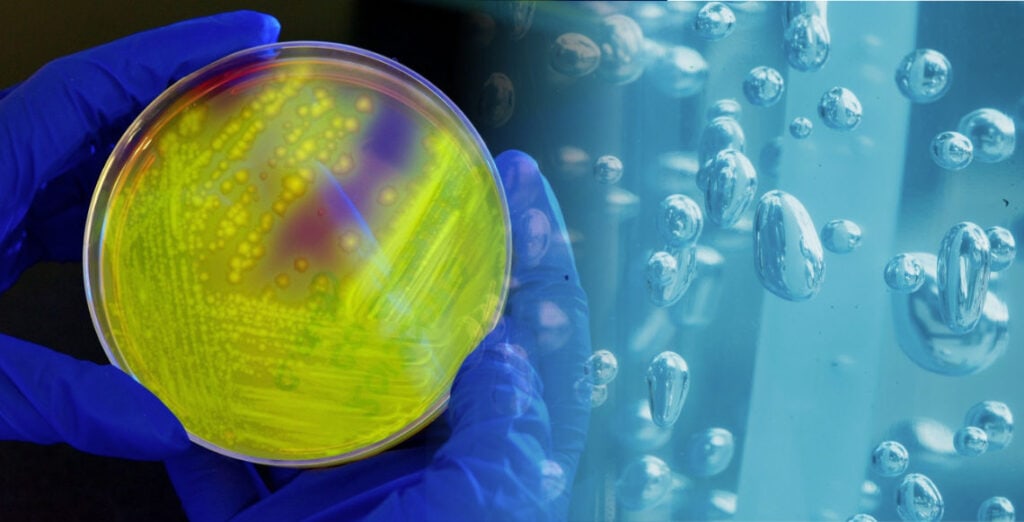
Prod Innovation Feb22 hero

7 New Developments that Add Value and Boost Sustainability
An Alternative to Antimicrobial Finishes
Sciessent (USA) has introduced NOBO anti-odour technology, specifically formulated for natural and synthetic fabrics. NOBO adsorbs compounds responsible for body odor without the use of an antimicrobial.
It is bluesign approved and listed on the Zero Discharge of Hazardous Chemicals (ZDHC) Foundation ZDHC Gateway, complying with ZDHC Level 3 requirements.

Login to read about these Top PRODUCT INNOVATIONS & DEVELOPMENTS.